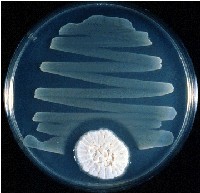

提起抗生素,今天可能没有人不知道。得了肺炎,用青霉素或者其他抗生素可以很快治疗好;伤口发炎,常常也要用抗生素。的确,人类战胜疾病,特别是与致病微生物的感染作斗争,抗生素起到并且还在发挥着重要作用。有人估计,由于抗生素的发明,全人类的平均寿命增加了10岁。抗生素是怎样发现和变成造福人类的药品的呢?让我们慢慢道来。
1929年英国细菌学家弗莱明在培养皿中培养细菌时,发现从空气中偶然落在培养基上的青霉菌长出的菌落周围没有细菌生长。他认为是青霉菌产生了某种化学物质,分泌到培养基里抑制了细菌的生长。这种化学物质便是最先发现的抗生素——青霉素。在第二次世界大战期间他和另外两位科学家经过艰苦难努力,终于把青霉素提取出来制成了制服细菌感染的特效药品。因为在战争期间,防止战伤感染的药品是十分重要的战略物资,所以,美国把青霉素的研制放在同研制原子弹同等重要的地位。1943年,这个消息传到中国,当时还在抗日后方从事科学研究工作的微生物学朱既明,也从长霉的皮鞋上分离到了青霉菌,并且用这种青霉菌制造出了青霉素。1947年,美国微生物学家瓦克曼又在放线菌中发现、并且制成了治疗发现了近万种抗生素。不过它们之中的绝大多数毒性太大,适合作为治疗人类或牲畜传染病的药品还不到百种。后来人们发现,抗生素并不是都能抑制生物生长,有些是能够抑制寄生虫的,有的能够除,有的可以用来治疗心血管病,还有的可以抑制人体的免疫反应,可以用在器官移植手术中。在20世纪90年代以后,科学家们把抗生素的范围扩大了,给了一个新的名称,叫做生物药物素。